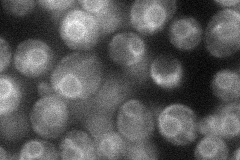
YPR138C
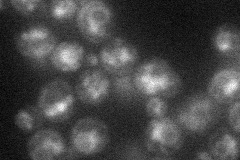
YPR138C
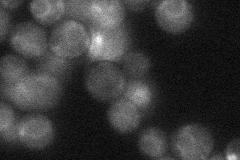
YPR138C
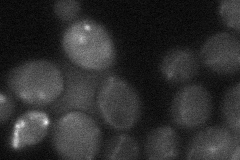
YPR138C
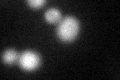
YPR138C

View description
Ammonium permease of high capacity and low affinity; belongs to a ubiquitous family of cytoplasmic membrane proteins that transport only ammonium (NH4+); expression is under the nitrogen catabolite repression regulation ammonia permease
Localization:
Intensity:
Fold change:
Significance:
-
C’ GFP library in SD

cell periphery28.65 -
N' NOP1pr-GFP in SD
ER35.832 -
N' TEF2pr-mCherry in SD
ER,vacuole23.8509 -
N' NATIVEpr-GFP in SD
ER26.4823 -
N' TEF2pr-VC and Cyto-VN in SD
below threshold23.6866 -
C’ GFP library in SD+DTT
cell periphery22.050.76No -
C’ GFP library in SD+H2O2

cell periphery24.760.86No -
C’ GFP library in Starvation Media

cell periphery20.630.72Yes -
C’ GFP library on the background of Pup2-DaMP

cell periphery -
C’ GFP library on the background of CCT mutant

cell periphery32.59961.13747No
